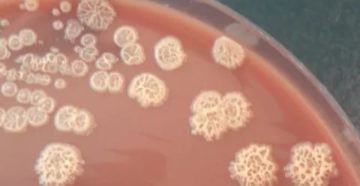
Pseudomonas stutzeri Pseudomonas stutzeri

Вазотомия носовых раковин: стоимость радиоволновой операции и отзывы о ней, восстановление после нее и как…
Рубрика “Лор”
Категория: Лор
Родительская категория:
Тугоухость лечение, причины, симптомы: Тугоухость 1 2 3 4 степени у ребенка Тугоухость — это…
Фарингит. Это следует знать каждому Такое заболевание, как фарингит, представляет собой воспалительный процесс, который развивается…
Выделения из носа: гнойные, желтые, зеленые, белые — Врач Невролог Избыточное жидкостное содержимое – экссудат…
Восстановление после септопластики и возможные осложнения Затрудненное носовое дыхание, храп, кровотечения и часто повторяющиеся заложенность носа…
Золотистый стафилококк в горле у взрослых и детей: причины, признаки, диагностика и методы лечения По…
Перевод pseudomonas stutzeri с английского на русский 1 pseudomonasПерсональный Сократ > pseudomonas 2 Pseudomonas псевдомонады…
Септопластика: почему не дышит нос? Послеоперационный период септопластики сопряжен с некоторыми неудобствами для пациента. Во-первых,…
Одна ноздря заложена: причины постоянного заложения ночью без насморка, почему слезится глаз и что делать…
Фарингит при беременности: как лечить и влияние на плод Обычно заболевания горла не приносят особых…